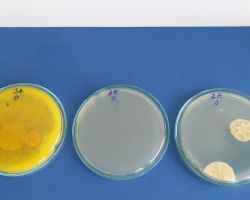

Centre of polymer systems’ scientist win The Vizionář 2021 award
Zlín, 19 May 2022 - The Vizionáři 2021 (Visionaries 2021) prize was awarded to the scientists for the AlterBio project, which aims to research, develop and propose the commercialization of innovative antimicrobial systems for plastics, coatings, beauty products and textiles. Antimicrobial components can be bonded to polymer systems so that they protect only the surface of the material and have no environmental impact. In this way, long-term antimicrobial protection of treated materials can be achieved without adverse health and environmental impacts.


Companies and organizations active in different sectors teamed up, making it possible to address several different areas within a single project. In addition to private companies Synpo, Centrum organické chemie, Biomedica, Fatra and INOTEX, the State Institute of Health in Prague and Palacký University in Olomouc, they included Tomas Bata University in Zlín.
The Zlín university’s team – part of the Environmental Technologies research group – was chiefly involved, in cooperation with Fatra Company, in the field of applying alternative, environmentally friendly antimicrobial substances into the structure of plastics. There was also cooperation with the State Institute of Health in terms of optimising and unifying methodologies for antimicrobial testing of such systems.
“An integral part of the research activities was detailed testing of the material and processing properties of the novel ingredients under development; the aim here was to improve the economic and environmental aspects of production,” says Dr. Martina Pummerová of CPS.
“The second project area investigated at CPS focused on antimicrobial coatings and varnishes, which can be defined as a layer that prevents microbial colonisation of the substrate. In the real life, the choice of the appropriate type of coating is critical for specific applications, especially with regard to the relationship between the required properties and cost. Within these activities, matrices based on thermoplastics were modified, in particular PET films for food packaging and various types of polyolefins,” further describes prof. Vladimír Sedlařík, supervisor of the Environmental Technologies research group.
The project outputs focus on transferring the results of laboratory research into the operational level. This transfer and fine-tuning of production, both are closely linked to the optimisation of production technology with long-term testing of the material properties of the products so that all development is directed towards the fine-tuning of these activities and transfer into industrial sectors.
The work described above was supported by the Technology Agency of the Czech Republic as part of the Competence Centres Programme (project ID: TE02000006); Ing. Kateřina Zetková of Synpo Company was the project leader. The research project activities were conducted between 2015 and 2019. Since then, the implementation of application-relevant outputs and their transfer into production has been underway.
The aim of the Vizionáři (Visionaries) project, which was organised by the CzechInno association for the eleventh year in the row, is to reward innovative projects and help commercialise innovative ideas. According to CzechInno's Executive Director Tereza Šamanová, the event’s objective is not only to recognise visionary projects, but also to offer their authors relevant links and contacts for cooperation. “Announcing the awards is not the end of the line here; everything goes on and is all about collaboration,” she said.
A total of 44 entries were submitted for year 11, coming from 11 administrative regions. “Many fields were represented; many projects were also the result of interdisciplinary cooperation. However, two areas stood out the most this particular year – environmental technologies and digitisation,” said Pavel Švejda, the chairman of the expert jury, member of Asociace inovačního podnikání (Association of Innovative Entrepreneurship of the Czech Republic).
CzechInno is a special-interest association of legal entities established in 2011 with the aim of effectively supporting innovation in the Czech business environment. The association is the author of a unique system of promoting innovations in Czech companies and the public sector, the owner of a number of regional, national and international projects focused on supporting the development of innovation, and the founder of the Central European Platform for Digital Innovation CzechInno and co-founder of the Hub for Digital Innovation.
Contact person:
Mgr. Petra Svěráková
Spokeswoman
Tomas Bata University in Zlín
Telephone: +420 777 852 440